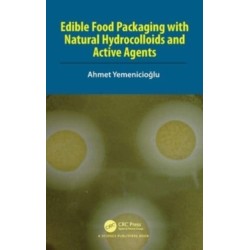
Edible Food Packaging with Natural Hydrocolloids and Active Agents

Ingen varer
Litteraturstudier: fra 1900 til 2000 igen
Der er 2+ underkategorier
Industriel kemi og produktionsteknologi
Visning: Type : Alle | Sprog : Alle | Format : Alle
-
Bemærk: Kan ikke leveres før jul.
Technology Innovation: Models, Dynamics, and Processes (Bog, Paperback / softback, Engelsk)Technology Innovation discusses the fundamental aspects of processes and structures of technology innovation. It offers a new perspective concerning fundamentals aspects not directly involved in the complex relations existing between technology and the socio-economic system.
Levering: Skaffevare (forvent 14 - 30 hverdage) -
Bemærk: Kan ikke leveres før jul.
Extremophiles: Wastewater and Algal Biorefinery (Bog, Paperback / softback, Engelsk)This book ‘Extremophiles: Wastewater and Algal Biorefinery’ explores the potential of extremophiles/extremotolerant organisms in wastewater treatment, biorefining of algal biomass and in the treatment of industrial waste effluent.
Levering: Skaffevare (forvent 14 - 30 hverdage) -
Bemærk: Kan ikke leveres før jul.
Edible Food Packaging with Natural Hydrocolloids and Active Agents (Bog, Paperback / softback, Engelsk)The book provides readers with state-of-the-art developments in antimicrobial, antioxidant and bioactive packaging based on natural hydrocolloids and active agents.
Levering: Skaffevare (forvent 14 - 30 hverdage) -
Bemærk: Kan ikke leveres før jul.
Cultivation for Climate Change Resilience, Volume 1: Tropical Fruit Trees (Bog, Paperback / softback, Engelsk)This book focuses on the management of some key tropical fruit species, mitigation strategies and technological counter-measures taken by researchers, progressive growers and commercial companies to face the challenge of climate change.
Levering: Skaffevare (forvent 14 - 30 hverdage) -
Bemærk: Kan ikke leveres før jul.
Blockchain-Enabled Resilience: An Integrated Approach for Disaster Supply Chain and Logistics Management (Bog, Paperback / softback, Engelsk)This book provides a first-of-its-kind approach for managers and policy-makers as well as... Læs mere
Levering: Skaffevare (forvent 14 - 30 hverdage) -
Bemærk: Kan ikke leveres før jul.
Thin-Films for Machining Difficult-to-Cut Materials: Challenges, Applications, and Future Prospects (Bog, Paperback / softback, Engelsk)This book presents balanced blend of principles and characteristics of machining of difficult-to-cut... Læs mere
Levering: Skaffevare (forvent 14 - 30 hverdage) -
Bemærk: Kan ikke leveres før jul.
The Other Side of Safety: Moving from Results-Based to Behavior-Based Safety (Bog, Paperback / softback, Engelsk)The text identifies and clarifies the clandestine methods of Results Based Safety (RBS) from Behavior Based Safety (BBS) as... Læs mere
Levering: Skaffevare (forvent 14 - 30 hverdage) -
Bemærk: Kan ikke leveres før jul.
High Performance Tensegrity-Inspired Metamaterials and Structures (Bog, Paperback / softback, Engelsk)Novel metamaterials with extraordinary properties, smart materials and structures, and adaptive systems with adjustable behaviour or... Læs mere
Levering: Skaffevare (forvent 14 - 30 hverdage) -
Bemærk: Kan ikke leveres før jul.
Good Laboratory Practice for Nonclinical Studies (Bog, Paperback / softback, Engelsk)This all-encompassing volume addresses every critical aspect of Good Laboratory Practice (GLP) regulations and demonstrates effective strategies for implementation in a variety of laboratory settings
Levering: Skaffevare (forvent 14 - 30 hverdage) -
Bemærk: Kan ikke leveres før jul.
Electrochemical Transformation of Renewable Compounds (Bog, Paperback / softback, Engelsk)Electrochemical conversion process can be used to generate power, store energy and synthesize chemicals, which plays a key role in the development of sustainable energy resources.
Levering: Skaffevare (forvent 14 - 30 hverdage) -
Bemærk: Kan ikke leveres før jul.
Rheology Applied in Polymer Processing (Bog, Paperback / softback, Engelsk)This book covers a wide range of topics in polymer rheology and will be very useful to both undergraduate and postgraduate students, as well as teachers and practicing rheologists.
Levering: Skaffevare (forvent 14 - 30 hverdage) -
Bemærk: Kan ikke leveres før jul.
Gypsum & Gypsum Products: Their Science & Technology (Bog, Paperback / softback, Engelsk)Highly detailed and elaborate, this book is written explicitly for professionals who work with gypsum in various technical and consumer centric field. The... Læs mere
Levering: Skaffevare (forvent 14 - 30 hverdage)

 for at udvide
kategorilisten.
for at udvide
kategorilisten.